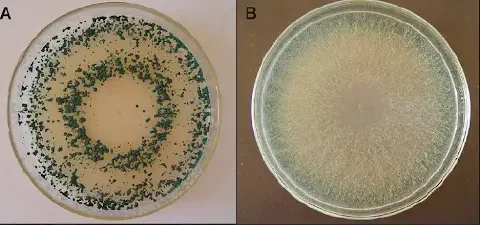
Imagem mostra fungo trichoderma em uma placa de vidro. O fungo possui coloração verde.

Índice
- O que são e como funcionam os biofungicidas?
- Como os biofungicidas são desenvolvidos?
- Como os biofungicidas atuam nas culturas?
- Prós e contras do uso de biofungicidas
- Como encontrar produtos no mercado nacional
- Conclusão
- Glossário
- Como otimizar o uso de biofungicidas na sua gestão
- Perguntas Frequentes
- Qual a principal diferença entre um biofungicida e um fungicida químico tradicional?
- Biofungicidas são tão eficientes quanto os fungicidas químicos?
- Posso misturar biofungicidas com defensivos químicos no mesmo tanque de pulverização?
- Quais os cuidados de armazenamento necessários para os biofungicidas?
- O uso de biofungicidas é seguro para o aplicador e o meio ambiente?
- Em quanto tempo os biofungicidas começam a fazer efeito na lavoura?
- Artigos Relevantes
As doenças que atacam as plantas podem se tornar um grande obstáculo para o sucesso da sua lavoura, principalmente quando o manejo não é feito da forma correta e no tempo certo.
Ao mesmo tempo, a sociedade busca cada vez mais por alimentos com menos resíduos de produtos químicos, o que torna o controle de doenças um desafio ainda maior para o produtor.
Nesse cenário, os biofungicidas surgem como uma solução eficiente e de baixa toxicidade. Eles podem ser usados no controle das principais doenças que afetam as culturas agrícolas, aliando produtividade com sustentabilidade.
Neste artigo, você vai entender em detalhes o que são os biofungicidas, como eles funcionam na prática e como consultar os produtos disponíveis no mercado para a sua lavoura. Boa leitura!
O que são e como funcionam os biofungicidas?
Biofungicidas são produtos biológicos formulados a partir de microrganismos vivos, como fungos e bactérias, que são utilizados para controlar doenças em plantas causadas por outros fungos e bactérias prejudiciais (patogênicos).
Com a crescente demanda por alimentos mais saudáveis e a busca por práticas agrícolas sustentáveis, soluções como os bioinsumos estão ganhando cada vez mais espaço. Os biofungicidas são uma categoria importante dentro desse grupo.
Essencialmente, eles funcionam de duas maneiras principais:
- Ação Direta: Os microrganismos do produto atuam diretamente sobre os patógenos que causam doenças, impedindo que eles se desenvolvam e infectem a planta.

- Controle Biológico: Fungos e bactérias benéficos, que não causam mal à lavoura, são aplicados na planta. Ao entrarem em contato com o patógeno, eles competem por espaço e nutrientes ou liberam substâncias que o enfraquecem, agindo como fungicidas naturais.
Como os biofungicidas são desenvolvidos?
O processo de criação de um biofungicida começa no próprio campo. Os microrganismos utilizados são encontrados na natureza, onde já atuam como predadores de outros microrganismos.
Essas espécies promissoras são isoladas e levadas para laboratório, onde passam por estudos rigorosos para garantir sua eficácia no controle de doenças específicas e sua segurança para o meio ambiente e para a cultura.
Para que um produto chegue ao mercado, ele precisa ser avaliado e aprovado por três órgãos reguladores: o MAPA (Ministério da Agricultura, Pecuária e Abastecimento), o Ibama e a Anvisa. Esse é um processo detalhado e que pode levar tempo, garantindo a qualidade e a segurança do produto final.
Somente após a comprovação de sua eficiência e confiabilidade, o biofungicida recebe o registro. A partir daí, os microrganismos são reproduzidos em escala industrial e de maneira controlada para a fabricação dos produtos que você encontra no mercado.
Como os biofungicidas atuam nas culturas?
Os biofungicidas são versáteis e podem ser aplicados de duas formas principais: no tratamento de sementes, protegendo a planta desde o início, ou pulverizados diretamente sobre as folhas durante o ciclo da cultura.
Quando o produto entra em contato com a planta ou com o patógeno, ele inicia o processo de controle da doença. Isso ocorre por meio de dois mecanismos principais:
- Ação direta: O microrganismo benéfico produz substâncias antibióticas e antifúngicas que atacam o patógeno, impedindo seu crescimento, infecção e reprodução na planta.
- Ação indireta: O agente biológico estimula as defesas naturais da própria planta, tornando-a mais resistente ao ataque do patógeno.
Esses microrganismos benéficos produzem compostos chamados metabólitos secundários, que têm ação direta contra as bactérias e fungos que causam doenças. A pesquisa é focada em encontrar microrganismos cujas substâncias liberadas sejam eficientes contra os patógenos, mas totalmente seguras para as plantas.
Controle de doenças causadas por fungos de solo
Um dos microrganismos mais estudados e utilizados na produção de biofungicidas são os fungos do gênero Trichoderma.
Eles são extremamente eficientes no controle de doenças causadas por fungos de solo em culturas de grande importância, como soja, cana-de-açúcar, algodão e hortaliças. Essas doenças geralmente afetam raízes, a base do caule e o sistema vascular, causando problemas sérios como murchas e podridões.
Existe uma grande expectativa sobre o uso do Trichoderma para controlar doenças de difícil manejo, como o mofo-branco na soja, a fusariose e a podridão radicular.
Além do controle de doenças, estudos da Embrapa mostram que o Trichoderma também traz outros benefícios, como a promoção do crescimento das plantas e o aumento da produtividade.
Isso acontece porque ele melhora a disponibilidade de nutrientes no solo para as plantas, através da ação de enzimas que solubilizam fosfatos e matéria orgânica. Algumas linhagens de Trichoderma também produzem hormônios que promovem o crescimento das raízes e da parte aérea.
Prós e contras do uso de biofungicidas
Como toda ferramenta de manejo, os biofungicidas apresentam vantagens e desvantagens. É importante conhecê-las para tomar a melhor decisão para a sua propriedade.
Vantagens
- Aplicação Familiar: A pulverização pode ser feita com os mesmos equipamentos e práticas tradicionais de aplicação de fungicidas.
- Sustentabilidade: Reduz a necessidade de usar agroquímicos, diminuindo o risco de contaminação do solo, da água e do aplicador.
- Alimento Mais Saudável: Os alimentos produzidos apresentam menor concentração de resíduos químicos.
- Redução de Custos: Pode diminuir os custos no controle de doenças a longo prazo.
- Eficiência Comprovada: Oferece um controle eficiente para diversas doenças importantes.
- Benefícios Adicionais: Muitos produtos também atuam como promotores de crescimento das plantas.
- Manejo Integrado: É uma excelente opção para ser incluída no Manejo Integrado de Doenças (MID).
Desvantagens
- Menor Número de Pesquisas: A área ainda tem menos pesquisas disponíveis quando comparada aos fungicidas químicos tradicionais.
- Prazo de Validade: Os produtos biológicos geralmente têm um prazo de validade menor.
- Cuidados Especiais: Exigem maior cuidado no armazenamento, transporte e manuseio para garantir a sobrevivência dos microrganismos.
Ainda há um caminho a ser percorrido para que os biofungicidas se tornem uma ferramenta prioritária no controle de doenças no Brasil. No entanto, com o avanço dos estudos e da tecnologia, o agronegócio brasileiro tem potencial para se tornar líder nesse segmento.
Como encontrar produtos no mercado nacional
Existem diversos biofungicidas comerciais disponíveis no mercado brasileiro. A forma mais segura de consultá-los é através da plataforma Agrofit, do Ministério da Agricultura, Pecuária e Abastecimento.
Siga este passo a passo para fazer a consulta:
- Acesse o site do sistema Agrofit.
- No menu, clique na opção “Produtos formulados”.
- No campo “Classe”, selecione a opção “Fungicida microbiológico”.
- Clique no botão “Consultar”.
A plataforma irá exibir uma lista com todos os biofungicidas que possuem registro no Brasil, mostrando os microrganismos aprovados e os produtos comerciais disponíveis.
Os produtos utilizam diferentes espécies de microrganismos. Entre os mais comuns, estão:
Baseados em Bacillus spp.
- Sonata: Indicado para o controle de oídio, mofo-cinzento, podridão-olho-de-boi, antracnose, mancha-púrpura e pinta-preta.
- Ataplan: Utilizado via pulverização para controle de antracnose, fusariose, tombamento da soja e podridão do colo.
Baseados em Trichoderma spp.
- Tricho-Turbo: Atua no controle de tombamento, mancha-de-fusarium, mofo-branco e também possui ação nematicida.
Esses produtos podem ser utilizados para o controle das respectivas doenças em uma ampla variedade de culturas.
Os biofungicidas são classificados com tarja verde, indicando que são pouco perigosos do ponto de vista toxicológico e ambiental. Mesmo assim, é fundamental seguir todos os procedimentos de segurança durante a aplicação. Utilize sempre o Equipamento de Proteção Individual (EPI) recomendado e siga as orientações da bula e do receituário agronômico.
Conclusão
Os biofungicidas são uma excelente alternativa para o manejo de doenças, permitindo evitar o uso excessivo de produtos químicos mais tóxicos.
Apesar de ainda estarem se popularizando no modelo de produção agrícola brasileiro, eles oferecem inúmeras vantagens, como a redução de custos, a melhora da qualidade dos alimentos e a promoção de um sistema agrícola mais sustentável.
Lembre-se sempre de tomar todos os cuidados necessários ao manusear e aplicar qualquer produto em sua lavoura. Em caso de dúvida, consulte sempre um engenheiro-agrônomo de sua confiança.

Glossário
Biofungicidas: Produtos de origem biológica, formulados com microrganismos vivos (como fungos e bactérias benéficos), utilizados para controlar doenças em plantas causadas por patógenos. Atuam como uma alternativa sustentável aos fungicidas químicos.
Bioinsumos: Categoria ampla de produtos para a agricultura desenvolvidos a partir de microrganismos, extratos de plantas ou outros materiais orgânicos. Incluem biofungicidas, bioinseticidas e biofertilizantes, focando em uma produção mais sustentável.
Controle Biológico: Estratégia de manejo que utiliza organismos vivos (inimigos naturais) para controlar pragas e doenças. No caso dos biofungicidas, usam-se fungos e bactérias benéficos para combater os microrganismos que prejudicam a lavoura.
Manejo Integrado de Doenças (MID): Uma abordagem estratégica que combina diferentes métodos de controle (biológico, químico, cultural e físico) para manter as doenças abaixo do nível de dano econômico. O uso de biofungicidas é um componente importante do MID.
MAPA (Ministério da Agricultura, Pecuária e Abastecimento): Órgão do governo federal brasileiro responsável por regulamentar e fiscalizar o setor agropecuário. É uma das três entidades que aprovam o registro de biofungicidas no país, garantindo sua eficácia e segurança.
Metabólitos secundários: Compostos químicos produzidos por microrganismos que não são essenciais para seu crescimento, mas que possuem funções específicas, como ação antibiótica ou antifúngica. São essas substâncias que, nos biofungicidas, atacam diretamente os patógenos.
Patógenos: Microrganismos, como fungos e bactérias, que causam doenças nas plantas. O objetivo dos biofungicidas é controlar a ação desses agentes para proteger a saúde e a produtividade da cultura.
Trichoderma: Gênero de fungo benéfico amplamente utilizado na produção de biofungicidas. É especialmente eficaz no controle de doenças causadas por fungos de solo, além de promover o crescimento das raízes e a absorção de nutrientes pelas plantas.
Como otimizar o uso de biofungicidas na sua gestão
Adotar biofungicidas é um passo importante para uma lavoura mais sustentável, mas o sucesso dessa estratégia depende de um bom planejamento e controle. Desafios como o prazo de validade mais curto dos produtos e a necessidade de monitorar a eficácia e os custos podem dificultar a transição. Ferramentas de gestão agrícola como o Aegro ajudam a superar esses obstáculos.
Com um software especializado, você pode registrar todas as aplicações, controlar o estoque de insumos biológicos em tempo real para evitar perdas e comparar os custos do manejo sustentável com o convencional. Isso permite tomar decisões baseadas em dados concretos, garantindo que a sustentabilidade também caminhe lado a lado com a lucratividade.
Que tal simplificar o manejo de insumos na sua fazenda?

Experimente o Aegro gratuitamente e veja na prática como otimizar seus custos e aumentar sua produtividade.
Perguntas Frequentes
Qual a principal diferença entre um biofungicida e um fungicida químico tradicional?
A principal diferença está na origem e no modo de ação. Biofungicidas utilizam microrganismos vivos (como bactérias e fungos benéficos) para controlar doenças de forma biológica, enquanto fungicidas químicos são compostos sintéticos. Além disso, os biofungicidas geralmente possuem menor impacto ambiental e não deixam resíduos tóxicos nos alimentos.
Biofungicidas são tão eficientes quanto os fungicidas químicos?
Sim, eles podem ser muito eficientes, especialmente quando usados de forma preventiva e dentro de um Manejo Integrado de Doenças (MID). Sua eficácia depende da aplicação correta e das condições ambientais. Em vez de uma ação de choque imediata, eles atuam de forma contínua, protegendo a planta e melhorando a saúde do solo.
Posso misturar biofungicidas com defensivos químicos no mesmo tanque de pulverização?
A compatibilidade varia muito entre os produtos. Alguns biofungicidas podem ser misturados com certos defensivos químicos, mas outros não. É fundamental sempre verificar a bula do produto para informações sobre compatibilidade de calda e, em caso de dúvida, consultar um engenheiro-agrônomo para evitar a inativação dos microrganismos.
Quais os cuidados de armazenamento necessários para os biofungicidas?
Como são produtos à base de organismos vivos, exigem cuidados especiais. Devem ser armazenados em local fresco, seco e ao abrigo da luz solar direta, evitando temperaturas extremas (muito altas ou muito baixas). Seguir rigorosamente as recomendações do fabricante na embalagem é crucial para garantir sua viabilidade e eficácia.
O uso de biofungicidas é seguro para o aplicador e o meio ambiente?
Sim, biofungicidas são considerados muito mais seguros. A maioria possui tarja verde, indicando baixa toxicidade para humanos e baixo impacto ambiental. Eles não contaminam o solo ou a água e são seletivos, preservando insetos benéficos. Mesmo assim, a utilização de Equipamento de Proteção Individual (EPI) durante a aplicação é sempre recomendada.
Em quanto tempo os biofungicidas começam a fazer efeito na lavoura?
Diferente dos químicos, a ação dos biofungicidas é mais gradual. Os microrganismos precisam de tempo para se estabelecer na planta ou no solo e iniciar sua atividade de controle. Os efeitos protetores começam logo após a aplicação, mas os resultados visíveis no controle da doença podem levar de dias a semanas, dependendo do patógeno e das condições da cultura.
Artigos Relevantes
- Por que o controle biológico com Trichoderma pode ser uma boa opção para sua lavoura: Este artigo é o aprofundamento ideal sobre o Trichoderma, o principal fungo benéfico citado no guia. Enquanto o artigo principal apresenta o Trichoderma, este detalha seus quatro mecanismos de ação e fornece orientações práticas de aplicação, como temperatura ideal, transformando um conceito teórico em conhecimento acionável para o produtor.
- Fungos de solo: veja as principais causas e como evitá-los: O artigo principal posiciona os biofungicidas como uma solução eficaz contra fungos de solo. Este candidato complementa perfeitamente ao definir o problema em detalhes, apresentando os principais fungos patogênicos (Macrophomina, Fusarium, Sclerotinia) e os danos que causam, criando uma forte conexão de ‘problema-solução’ e reforçando a necessidade da tecnologia.
- O que são fungicida sistêmico e de contato e qual utilizar?: Para que o produtor entenda o valor dos biofungicidas, é crucial que ele conheça as ferramentas tradicionais. Este artigo explica as diferenças fundamentais entre fungicidas sistêmicos e de contato, conceitos essenciais para o Manejo Integrado de Doenças (MID) mencionado no texto principal. Ele oferece o contexto necessário para posicionar os biofungicidas de forma estratégica.
- O que são bioinsumos e como eles podem ajudar a reduzir custos: Este artigo oferece uma visão panorâmica, contextualizando os biofungicidas dentro da categoria mais ampla de bioinsumos. Ele expande a perspectiva do leitor para outras soluções biológicas (biofertilizantes, inoculantes), alinhando-se à tendência de sustentabilidade e redução de custos abordada no artigo principal, e mostrando que os biofungicidas são parte de um movimento maior.
- Agrofit: Conheça o maior banco de informações sobre defensivos do Brasil: O artigo principal recomenda o uso do sistema Agrofit para encontrar produtos, mas oferece apenas um guia básico. Este artigo é um tutorial completo e prático que ensina o produtor a dominar a ferramenta, transformando uma recomendação em uma habilidade concreta. Ele agrega um imenso valor prático, capacitando o leitor a aplicar o conhecimento adquirido imediatamente.